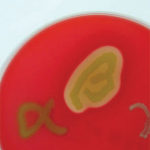

Oral Pathogens May Help Trigger Stroke Events
Researchers at Tampere University in Finland have found the presence of DNA from oral pathogens in the cerebral emboli of stroke patients, signifying the possible adverse effects of suboptimal oral health.
Researchers at Tampere University in Finland have found the presence of DNA from oral pathogens in the cerebral emboli of stroke patients, signifying the possible adverse effects of suboptimal oral health. Findings from the study, “Oral Bacterial Signatures in Cerebral Thrombi of Patients With Acute Ischemic Stroke Treated With Thrombectomy,” published in the Journal of American Heart Association, focus on the connection between the oral/systemic link and overall wellness.
The team analyzed thrombus aspirates removed from 75 stroke patients who received emergency treatment for acute ischemic stroke in the Acute Stroke Unit of Tampere University Hospital and found the majority of the aspirates contained pathogenic DNA, mainly from Streptococcus mitis. In addition to their role in the oral microbiota, once entering the circulatory system streptococcus bacteria act as pathogens that can cause infection of cardiac valves.
Among the 75 subjects who underwent thrombectomies, 84% of the blood clots tested positive for pathogenic DNA; of these, 79% had a strain of the streptococcus species, mainly the S. mitis group. Until additional research can further establish a link between oral pathogens and stroke, the authors emphasize oral health care as a primary preventive measure for atherothrombotic events.
From Dimensions of Dental Hygiene. September 2019;17(8):11.